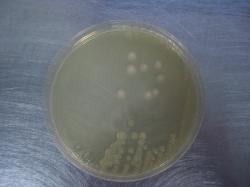

| Priestia (Bacillus) megaterium |
| Vacuolate / foamy cells. Bacillus megaterium |
| Bacillus megaterium old culture |
| Bacillus megaterium colonies on Mueller-Hinton agar |
Taxonomy
Morphology
Cultural characteristics
Biochemical characters
Ecology
Pathogenicity
References
Phylum Bacillota (Firmicutes), Class Bacilli, Order Caryophanales, Family Bacillaceae, Genus Priestia, Priestia megaterium (de Bary
1884) Gupta et al. 2020, type species of the genus.
Synonyms: Bacillus megaterium de Bary 1884, B. tumescens Zopf 1885, B. oxalaticus Migula 1894, B. ruminatus Gottheil 1901, B.
graveolens Gottheil 1901, B. petasites Gottheil 1901, B. silvaticus Neide 1904, B. malabarensis Lohnis and Pillai 1907, B. danicus
Lohnis and Westermann 1909, B. carotarum Koch 1888 (differs from typical members), possible synonyms of B. carotarum (B.
simplex Gottheil 1901, B. cohaerens Gottheil 1901, B. cobayae Stapp 1920, B. capri Stapp 1920, B. musculu Stapp 1920), B. flexus
Batchelor 1919 (but failling to produce acid from pentoses and to deaminate phenylalanine).
1884) Gupta et al. 2020, type species of the genus.
Synonyms: Bacillus megaterium de Bary 1884, B. tumescens Zopf 1885, B. oxalaticus Migula 1894, B. ruminatus Gottheil 1901, B.
graveolens Gottheil 1901, B. petasites Gottheil 1901, B. silvaticus Neide 1904, B. malabarensis Lohnis and Pillai 1907, B. danicus
Lohnis and Westermann 1909, B. carotarum Koch 1888 (differs from typical members), possible synonyms of B. carotarum (B.
simplex Gottheil 1901, B. cohaerens Gottheil 1901, B. cobayae Stapp 1920, B. capri Stapp 1920, B. musculu Stapp 1920), B. flexus
Batchelor 1919 (but failling to produce acid from pentoses and to deaminate phenylalanine).
Gram-positive, 2.0-5.0 x 1.2-1.5 μm, motile, peritrichous flagella. Spores are
ellipsoidal or spherical, central, paracentral or subterminal; not swelling the
sporangia. Capsule might be present. Cells grown on glucose agar produce large
amounts of storage material, giving a vacuolate or foamy appearance.
ellipsoidal or spherical, central, paracentral or subterminal; not swelling the
sporangia. Capsule might be present. Cells grown on glucose agar produce large
amounts of storage material, giving a vacuolate or foamy appearance.
Colonies are round to irregular, with entire to undulate margins. May become yellow
and then brown or black after prolonged incubation.
Hemolytic. Aerobic, do not grow anaerobically. Growth temperature from 3-20 ºC to
35-45 ºC. Optimum temperature is 30 ºC. The temperature range of a water isolate
from an Antarctic geothermal island was 17-63 °C, with an optimum of 60 °C.
On nutrient agar grow heaped and nonspreading, glossy, sometimes slightly
rugose;mucoid on glucose agar. Aged cultures may become yellow, brown or black.
Growth active at pH 5.7-7.0
Can grow in 7% NaCl. NaCl, allantoin or urate are not required for growth.
and then brown or black after prolonged incubation.
Hemolytic. Aerobic, do not grow anaerobically. Growth temperature from 3-20 ºC to
35-45 ºC. Optimum temperature is 30 ºC. The temperature range of a water isolate
from an Antarctic geothermal island was 17-63 °C, with an optimum of 60 °C.
On nutrient agar grow heaped and nonspreading, glossy, sometimes slightly
rugose;mucoid on glucose agar. Aged cultures may become yellow, brown or black.
Growth active at pH 5.7-7.0
Can grow in 7% NaCl. NaCl, allantoin or urate are not required for growth.
Spores occur in soil, feces. Isolated from foods and clinical specimens. Found in the
gut of a termite, Zootermopsis angusticollis. Antibiotic producer („megacin”). No
growth in the presence of lysozyme.
gut of a termite, Zootermopsis angusticollis. Antibiotic producer („megacin”). No
growth in the presence of lysozyme.
Considered to be not pathogenic or with low virulence. One report of soft tissue
infection of the right leg caused by Bacillus megaterium.
Used as biofertilizer in agriculture (admin note).
infection of the right leg caused by Bacillus megaterium.
Used as biofertilizer in agriculture (admin note).
- Bîlbîie V., Pozsgi N., 1985, Bacteriologie Medicală, vol.ll, Ed. Medicală, Bucureşti.
- Gordon R.E., Haynes W.C., Pang C.H. (1973) – The genus Bacillus . Agriculture Handbook No. 427, U.S.D.A., Washington D.C.
- Buchanan R.E., Gibbons N.E., Cowan S.T., Holt J.G., Liston J., Murray R.G.E., Niven C.F., Ravin A.W., Stanier R.W. ( 1974) – Bergey’
s Manual of Determinative Bacteriology, Eight Edition, The Williams & Wilkins Company, Baltimore. - Răducănescu H., Valeria Bica-Popii, 1986, Bacteriologie veterinară, Ed. Ceres, Bucureşti.
- N.A. Logan and P. De Vos, 2009. Genus I. Bacillus Cohn 1872. In: (Eds.) P.D. Vos, G. Garrity, D. Jones, N.R. Krieg, W. Ludwig, F.A.
Rainey, K.-H. Schleifer, W.B. Whitman. Bergey’s Manual of Systematic Bacteriology, Volume 3: The Firmicutes, Springer, 21-127. - Gupta RS, Patel S, Saini N, Chen S. Robust demarcation of 17 distinct Bacillus species clades, proposed as novel Bacillaceae
genera, by phylogenomics and comparative genomic analyses: description of Robertmurraya kyonggiensis sp. nov. and proposal
for an emended genus Bacillus limiting it only to the members of the Subtilis and Cereus clades of species. Int J Syst Evol Microbiol
2020; 70:5753-5798. - Bocchi MB, Cianni L, Perna A, Vitiello R, Greco T, Maccauro G, Perisano C. A rare case of Bacillus megaterium soft tissues infection.
Acta Biomed. 2020 Dec 30;91(14-S):e2020013. doi: 10.23750/abm.v91i14-S.10849. PMID: 33559642; PMCID: PMC7944702.
Positive results for catalase, hydrolysis of starch, utilization of citrate (depending on
method - admin note), hydrolysis of esculin, beta-galactosidase, phenylalanine
deamination, hydrolysis of gelatin, hydrolysis of casein, acid production from:
L-arabinose, N-acetyl-D-glucosamine, amygdalin, arbutin, D-cellobiose, D-fructose,
galactose, beta-gentibiose, meso-inositol, inulin, lactose, glycogen, glucose, glycerol,
maltose, D-mannitol, D-melibiose, D-raffinose, ribose, salicin, starch, sucrose,
trehalose, and D-xylose.
Negative results for Voges-Proskauer, indole production, arginine dihydrolase, lysine
decarboxylase, ornithine decarboxylase, tryptophan deaminase, hydrolysis of urea, egg
yolk reaction, acid production from: methyl beta-xyloside, D-arabinose, adonitol,
L-arabitol, dulcitol, erythritol, D- or L-fucose, 2- or 5-ketogluconate, lyxose, D-mannose,
rhamnose, and sorbose.
Variable results for oxidase, degradation of tyrosine, nitrate reduction, acid production
from: D-arabitol, gluconate, D-melezitose, sorbitol, and xylitol.
method - admin note), hydrolysis of esculin, beta-galactosidase, phenylalanine
deamination, hydrolysis of gelatin, hydrolysis of casein, acid production from:
L-arabinose, N-acetyl-D-glucosamine, amygdalin, arbutin, D-cellobiose, D-fructose,
galactose, beta-gentibiose, meso-inositol, inulin, lactose, glycogen, glucose, glycerol,
maltose, D-mannitol, D-melibiose, D-raffinose, ribose, salicin, starch, sucrose,
trehalose, and D-xylose.
Negative results for Voges-Proskauer, indole production, arginine dihydrolase, lysine
decarboxylase, ornithine decarboxylase, tryptophan deaminase, hydrolysis of urea, egg
yolk reaction, acid production from: methyl beta-xyloside, D-arabinose, adonitol,
L-arabitol, dulcitol, erythritol, D- or L-fucose, 2- or 5-ketogluconate, lyxose, D-mannose,
rhamnose, and sorbose.
Variable results for oxidase, degradation of tyrosine, nitrate reduction, acid production
from: D-arabitol, gluconate, D-melezitose, sorbitol, and xylitol.

(c) Costin Stoica

| Antibiogram |
| Encyclopedia |
| Culture media |
| Biochemical tests |
| Stainings |
| Images |
| Movies |
| Articles |
| Identification |
| Software |
| R E G N U M PROKARYOTAE |

| Back |